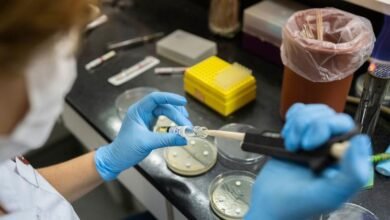

في
-
🩺صحة و جمال

7 وجبات خفيفة تساعد في ضبط مستوى السكر بالدم
لا يتأثر مستوى الغلوكوز في الدم بالأطعمة السكرية فحسب، وإنما كل شيء، من النوم إلى التوتر وكذلك الهرمونات. لكن تشير…
أكمل القراءة » -
🩺صحة و جمال

إنجاب الرجل في سن متقدم يزيد احتمال الطفرات الوراثية
وجدت دراسة جديدة أن عمر الأب يضيف خطراً وراثياً، لكن الاحتمالات الإجمالية لطفرات جينية تظل منخفضة لدى معظم العائلات. Source…
أكمل القراءة » -
🩺صحة و جمال

نوعان من التوابل يساعدان في إنقاص الوزن
يبذل كثيرون جهوداً لإنقاص الوزن، لتفادي مضاعفات السمنة التي تهدد صحة القلب والكبد إلى جانب أنها تزيد مخاطر الإصابة بالسكري…
أكمل القراءة » -
🩺صحة و جمال

علماء يكتشفون حاسة سادسة "مخفية" في جسم الإنسان
اكتشف فريق من العلماء الأمريكيين ما وصفوه بـ”الحاسة السادسة المخفية” في جسم الإنسان، في اكتشاف قد يغيّر فهمنا لطبيعة الإحساس…
أكمل القراءة » -
🩺صحة و جمال

فيتامين "ب 3" يساعد في مكافحة سرطان الجلد
وجدت دراسة واسعة النطاق أجريت على قدامى المحاربين الأمريكيين، وشملت أكثر من 33 ألف مشارك، أن النيكوتيناميد – وهو أحد…
أكمل القراءة » -
🩺صحة و جمال

منظمة الصحة العالمية في شرق المتوسط – أعلى تركيز لحالات الطوارئ وتكلفة التقاعس تُقاس بالأرواح المفقودة
جاء ذلك في تصريحاتها خلال افتتاح الدورة الثانية والسبعين للجنة الإقليمية للمنظمة، المقرر أن تُعقد على مدار الأيام الثلاثة المقبلة…
أكمل القراءة » -
🩺صحة و جمال

دراسة.. الإقلاع عن التدخين في مرحلة متقدمة من العمر قد يقي من الخرف
خلصت دراسة إلى أن الإقلاع عن التدخين، حتى في مرحلة متقدمة من العمر، يمكن أن يساعد في تباطؤ مشاكل الذاكرة…
أكمل القراءة » -
🩺صحة و جمال

حلوى شائعة تساهم في خفض ضغط الدم
يُعرف ارتفاع ضغط الدم، أو فرط الضغط، بأنه حالة يرتفع فيها ضغط الدم على جدران الشرايين بشكل خطر، وغالباً ما…
أكمل القراءة » -
🩺صحة و جمال

زيادة انتشار مقاومة مضادات الميكروبات، والذروة في شرق المتوسط
أصدرت منظمة الصحة العالمية التقرير الجديد اليوم الذي اعتمد على معلومات قدمتها أكثر من 100 دولة إلى “النظام العالمي لمراقبة…
أكمل القراءة » -
🩺صحة و جمال

أدوات في الحمّام لا يجب مشاركتها مع الآخرين أبداً
تعيش العديد من البكتيريا والفيروسات والفطريات المسببة للأمراض على الأقمشة والبلاستيك والأشياء المعدنية في الحمام. وبإمكان هذه الميكروبات المسببة للأمراض…
أكمل القراءة »